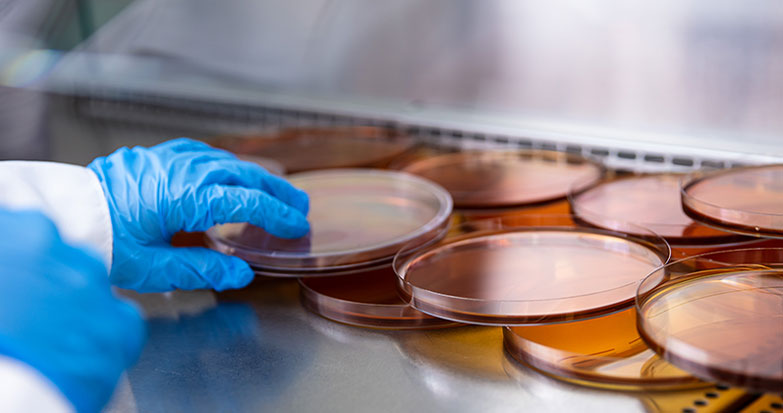

O maior laboratório
de Santa Catarina

Análises
Microbiológicas, Físico-Químicas, Microscópicas
e Biológicas em diversas matrizes.

Amostragens
Realizadas seguindo rigorosamente
todas as normas técnicas.

Dedicação ao cliente
Sob demanda desenvolvemos métodos customizados
para atendimentos específicos da indústria.


Escopo de ensaios
diversificado
Nosso escopo de ensaios acreditado é diversificado, e por estarmos sempre inovando, possuímos diversos outros ensaios validados e liberados para a comercialização que ainda não estão listados em nossa acreditação. Além de atendermos diversas matrizes, existe toda uma variedade de técnicas utilizadas para entregarmos uma solução completa para sua empresa.
Saber mais
Nossos diferenciais
Laboratório com 2.400m² de área construída em um terreno com 5.400m².
Quadro de colaboradores composto por pesquisadores especialistas e mestres.
Uma das maiores estruturas laboratoriais do Brasil.
Setor exclusivo para suporte técnico ao cliente.
Acessibilidade e relacionamento. Nosso atendimento é personalizado.
Atividade em tempo integral (não fechamos) e parceiros estratégicos no Brasil inteiro.
Se candidate aos testes sensoriais
Você pode ter uma experiência incrível realizando testes cegos em diversos produtos sem conhecer a sua marca.
Clique aquiÁrea do cliente
Acesse seus serviços
Treinamentos
anuais gratuitos
para clientes

Compartilhar o conhecimento é imprescindível
O Freitag Laboratórios oferece cursos técnicos especialmente para os clientes. Dessa forma, possibilitamos que os mesmos acompanhem processos e ensaios e tirem suas dúvidas diretamente com a equipe especializada.
Saiba mais sobre os treinamentos e inscreva-se!
Clique aqui
Tem alguma dúvida?
Criamos uma área especial com algumas perguntas frequentes. Se preferir, mande sua dúvida para nós. Será um prazer ajudá-lo!
Perguntas frequentesTrabalhe com o Freitag
Desenvolva sua jornada profissional em um dos melhores laboratórios do país, com um time que evolui constantemente!
Trabalhe conosco
















